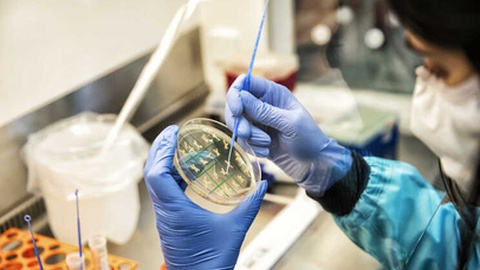
None

Portugal doou mais de 159 mil vacinas ao Vietname

O Vietname já recebeu 159.120 doses da vacina da Pfizer-BioNTech contra a covid-19, doadas por Portugal, anunciou a delegação da Fundo das Nações Unidas para a Infância (UNICEF) em Hanói.
Segundo um comunicado divulgado na terça-feira, a doação do governo português foi feita através do programa internacional de distribuição de vacinas anti-covid-19 para os países mais pobres COVAX.
"Portugal vai continuar a apoiar o setor da saúde do Vietname, (...) para assegurar o acesso equitativo do povo vietnamita à vacina contra a covid-19", referiu no comunicado Tran Kim Chung, cônsul honorário de Portugal na capital, Hanói.
Só este ano, o COVAX já entregou 6,27 milhões de doses ao Vietname, doadas pela Alemanha, Reino Unido, Portugal e Luxemburgo.
A representante da UNICEF no Vietname, Lesley Miller, agradeceu a contribuição "importante e em tempo útil" dos quatro países.
O COVAX é coliderado pela Organização Mundial de Saúde, a Cepi (Coalition for Epidemic Preparedness Innovations) e a Aliança Global para as Vacinas (GAVI, presidida por José Manuel Durão Barroso).
A 3 de dezembro, o ex-primeiro-ministro português disse à Lusa que o COVAX tinha prevista a entrega de mais de 1,2 milhões das cerca de 2,4 milhões de doses doadas por Portugal e que ainda não tinham sido encaminhadas para países recetores.
O plano previa que fossem encaminhadas 931.200 doses para Angola, 165.000 doses para a Etiópia e 14.400 para Vanuatu, referiu Durão Barroso.
O Vietname, que no início da pandemia adotou com sucesso uma política de "zero casos", alterou a estratégia, apostando na vacinação face à rápida disseminação da variante Delta.
Desde o início da pandemia, quase 2,2 milhões pessoas foram infetadas no Vietname e 37.010 morreram.
A covid-19 provocou 5.602.767 mortes em todo o mundo desde o início da pandemia, segundo o mais recente balanço da agência France-Presse.
A doença respiratória é provocada pelo coronavírus SARS-CoV-2, detetado no final de 2019 na China.
A nova variante Ómicron, classificada como preocupante e muito contagiosa pela OMS, foi detetada na África Austral e, desde que as autoridades sanitárias sul-africanas deram o alerta em novembro, tornou-se dominante em vários países, incluindo em Portugal.